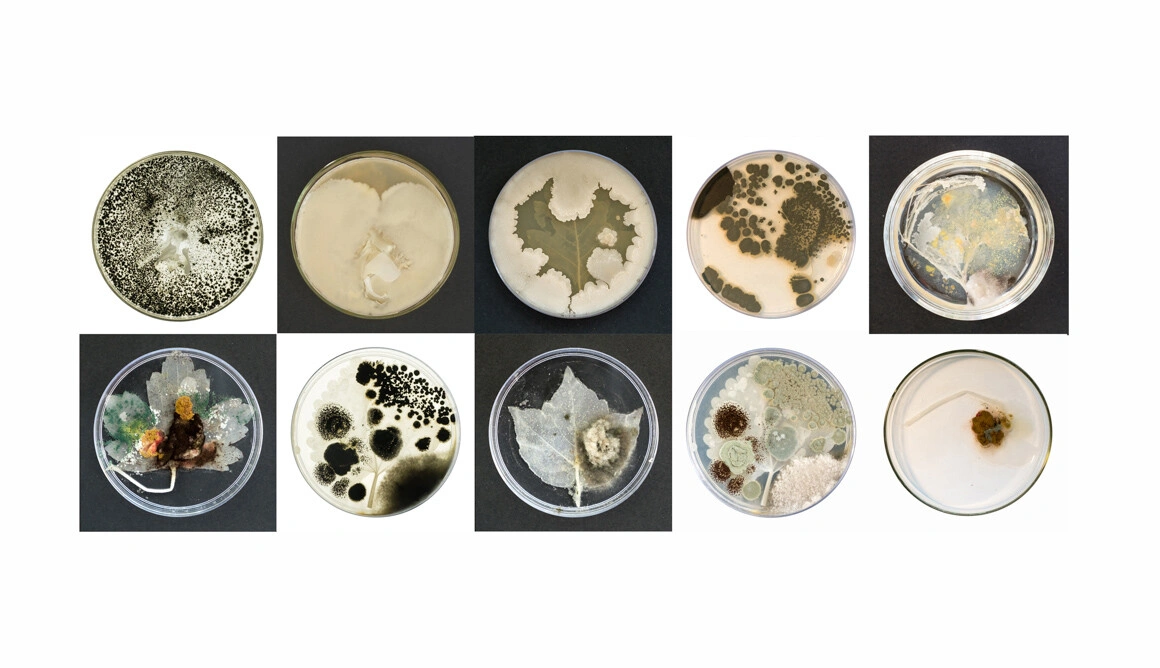

Când am văzut câteva frunze fantomatice pulsând într-un acvariu după bătăile inimii unei persoane reale, am simțit emoția aceea bizară pe care ți-o creează roboții intrați un pic prea mult în sufletul tău. Intrați la propriu în inimă. Eram în atelierul Floriamei Cândea de la Malmaison, într-o zi a porților deschise. Mi-a rămas mintea agățată de frunzele acelea și mi-am dorit să mă întorc, să stau de vorbă mai mult cu ea.
Floriama are 38 de ani, a studiat pictura la București, dar spune că n-a fost niciodată cu adevărat pictoriță. A fost atrasă dintotdeauna de fotografia experimentală și de chimie și aceasta e filiera pe care a ajuns la proiectele actuale în care experimentează cu afterlife-ul plantelor, cum îl numește ea.
Frunza fantomatică pe care am văzut-o prima dată în atelierul ei era o frunză decelularizată, o frunză din care artista a scos celulele, păstrând doar țesutul conjunctiv, adică matrița de celuloză, pe care a fost suprapusă o rețea de fibre electrofilate, ca o celuloză artificială. Un fel de mușchi artificial, după cum îmi explică ea, care a fost tratat cu o peliculă foarte subțire de aur și apoi electrolizat astfel încât frunzele să rămână reactive la umiditate. Multe dintre lucrările Floriamei sunt dependente de condiții de laborator sau sunt rezultatele unor experimente de laborator. Iar procesul în sine e mai interesant decât rezultatul final, din câte spune ea. De aceea nu e suficientă o etichetă pe lucrările ei pentru a le descrie, iar în timpul unui eveniment de tipul porților deschise, e nevoie ca ea să fie acolo să-și explice lucrările. „Dar mie îmi place să vorbesc”, zice.

Într-un proiect fotografic din 2018 numit Uncanny Symmetry, Floriama „s-a jucat” cu identitatea vizuală a obiectelor. A folosit două materiale diferite, o bucată de carne și o bucată de piatră, și s-a întrebat cât de mult poate reduce detaliile astfel încât obiectele să se camufleze unele în altele, să fie greu de depistat la o primă vedere. Carnea, cumpărată de la piață, a fost transformată: a scos din ea celulele și a păstrat doar colagenul, astfel încât carnea a devenit albă, mată, ca o rocă arsă de soare. Floriamei i-a plăcut ideea de a crea un obiect greu de recunoscut după ce este epurat de detalii. A descoperit în urma acestui proiect și procedura prin care sunt pregătite organele pentru transplant (golite de celule și apoi umplute cu celulele gazdei, pentru a fi mai ușor acceptate de noul corp) și i s-a părut că aceasta i-a susținut și mai bine ideea privării de identitate.
Genul acesta de întâlnire cu oameni pentru care pare că totul e posibil în materie de artă te face pe tine, scriitorul, să realizezi cât ești de limitat de materialul tău de lucru. Sau poate că e mai important curajul de a dezmembra obiecte în copilărie (după cum mărturisește Floriama) decât arta pe care o alegi mai târziu ca formă de exprimare? Îmi spune că-i place mult să demonteze obiecte (ca răspuns la întrebarea mea „Ce te încarcă artistic, cu ce te hrănești?”), încă de când era mică, îi place să meargă la târgul de vechituri de la Valea Cascadelor, să caute piese, motoare, sticlărie, lucruri pe care le cumpără pentru că-i plac și pe care apoi le ține minte în detaliu, iar în timp, când îi trebuie componente pentru vreun proiect anume, știe exact de unde să le ia.

Unele dintre lucrările pe care le-am văzut pe site-ul ei m-au dus cu gândul la laboratorul de biologie din școală, într-un timp care s-a suprapus cu copilăria, într-o vreme când zilele erau lungi și noi aveam timpul și răbdarea de a ne lăsa fascinați de forfota celulelor în foile de ceapă la microscop sau de liliacul împăiat care nu înțelegeam ce caută în insectarul acela de pe etajera cea mai de sus din laborator.
Floriama îmi spune că primele încercări cu decelularizarea au venit în urma unei rezidențe artistice la Trieste. Întoarsă acasă, a luat o inimă de vită de la Piața Obor, l-a rugat pe măcelar să o taie cu o aortă mai lungă, fiindcă îi trebuiau vasele de sânge ca să poată pompa în ea enzime, lichide și detergenți de laborator. A fost nevoie să treacă prin multe variante până să obțină o inimă curată.
Lucrările ei rezistă bine în timp; cele organice sunt păstrate în soluție de laborator, majoritatea în atelierul de la Malmaison, dar mai lucrează și acasă, dacă lucrările (pe care îmi vine să le numesc „preparate”) trebuie manevrate repede și e nevoie de chiuvetă la îndemână (la Malmaison, băile sunt pe hol).
Nu-i pare rău să se despartă de lucrări, fiindcă sunt bine documentate foto și video. Și evident că și-ar dori să vândă mai multe, îmi spune, fiindcă astfel și-ar putea cumpăra alte materiale de lucru, cu care să experimenteze pentru alte proiecte. În punctul acesta nu pot să nu întreb din ce trăiește. Asta ne întrebăm unii pe alții mereu, deși recunosc că pe mine mă cam irită. Probabil că oamenii sunt pur și simplu curioși, dar pentru mine întrebarea asta are în ea implicită o acuzație de lene.
Floriama îmi povestește despre asociația culturală Qolony, pe care o are împreună cu artistele Mihaela Ghiță și Sabina Suru. Fac proiecte interdisciplinare de artă și știință, lucrează cu ingineri și cercetători și au, printre altele, și câteva parteneriate cu institute de la Măgurele. În plus, organizează o rezidență pentru artiști care lucrează cu concepte sau metode științifice și fac multe proiecte care au și o parte de cercetare. E „operator cultural independent”, îmi spune ea, și râdem amândouă. Și eu sunt „lucrător cultural independent”, denumire împământenită rapid după noul cod fiscal din 2018. Fiindcă arta n-o fi muncă, dar iată că ANAF-ul, în înțelepciunea lui, ne face dreptate și ne numește lucrători.

Nici după „ciornele” menite să fie dezasamblate nu-i pare rău, îmi spune Floriama, continuând discuția despre despărțirea de lucrări. Am văzut la unii artiști vizuali atunci când se despărțeau de lucrări o anumită bucurie, pe care eu o admir, fiindcă o citesc ca pe un fel de tărie de caracter, dar probabil că e altceva. Cu toate lamentările mele legate de limitările literaturii și cu toate că mi se pare mai puțin dinamică (de produs și de consumat) decât alte arte, un lucru care-mi place enorm la literatură e că nu trebuie să mă despart de lucrare. Că în orice moment al vieții mele pot să întind mâna și să iau de pe un raft (chiar dacă e un raft de la mine din casă și e singurul din lume pe care se află cărțile) o variantă mai veche a mea, un peisaj sufletesc al meu de demult. Mi-e greu să recitesc din cărțile mai vechi, dar simplu fapt că știu că ele sunt acolo îmi dă un sentiment de siguranță, ele sunt elementele care țin laolaltă franjurile acelea din CV.
O întreb pe Floriama ce dificultăți are atunci când expune lucrările, dat fiind că depind atât de mult de mediu și sunt fragile. Îmi spune că poate avea mici accidente, se poate întâmpla ca ceva să nu meargă și să aibă nevoie de o reparație, de lipit un nou circuit de exemplu, iar mare parte din reparații le face ea însăși. Și codurile le scrie tot ea, dar dacă are nevoie de ceva complex, apelează la specialiști. Dificultatea cea mai mare, îmi spune, e mai degrabă că trebuie să fie prezentă la instalare și dezinstalare – lucrările ei conțin circuite, cabluri, e greu să dea cuiva instrucțiuni despre cum să le asambleze. Dacă are lucrări achiziționate, va trebui să facă mentenanță periodic, fiindcă se mai ard circuite. E genul de artist, zice, care trebuie să vină o dată la șase luni să-și verifice lucrarea. Dacă totul e în regulă, cel mai probabil n-a fost pusă în funcțiune prea mult.
A vândut până acum câteva lucrări mici pentru colecții particulare. Pentru lucrările mari, precum acvariul care face valuri, e greu să găsești loc. Acvariul e acolo, în atelier, ea se ridică și-l pune în funcțiune și-mi explică ce se întâmplă. Valurile sunt generate în funcție de bătăile inimii cuiva, iar momentan funcționează cu un puls preînregistrat. Însă va avea un senzor pulsoximetru (care are o carcasă de pulsoximetru medical, dar în interior un senzor conectat la softul Arduino), iar vizitatorii vor putea pune degetul în acel „clește” și mecanismul va genera valuri în funcție de pulsul lor.

Floriama îmi spune că-i place să creeze obiecte care să preia din fiziologia oamenilor din jur, a lucrat cu senzori care măsoară tot felul de parametri fiziologici: puls, EEG, conductivitatea pielii. Pulsul e cel mai spectaculos, pentru că e direct legat de ideea de viață, așa că acum caută soluții să citească pulsul la distanță, prin metode cât mai neinvazive, cum ar fi de exemplu cu ajutorul unui fascicul laser sau cu o cameră video care să detecteze ce se întâmplă cromatic cu capilarele, la nivelul pielii. E un pic SF ce-mi povestește și Floriama îmi spune că de fapt citește mult SF, îi place partea speculativă, acolo unde granițele dintre știință și imaginație nu sunt clare. Și știința a avut episoade speculative de-a lungul vremii, așa că și trecutul științei are ceva SF dacă ne uităm la el din punctul în care ne aflăm astăzi, spune ea.
Faptul că nu e cercetătoare îi dă libertatea de a-și pune imaginația la contribuție atunci când face experimente. Dar uneori drumul până la lucrarea finală e lung. În cazul acvariului, i-a luat ceva mai mult timp pentru a-și da seama că are nevoie de un alt plan pentru „fundul mării” pentru a obține niște valuri „curate”. Cu un plan drept, valurile ieșeau foarte haotice. Însă ce o pasionează cel mai mult e chiar acest drum. Îi place să caute.
Despre un proiect în curs îmi spune că e deocamdată în faza de rețea de cabluri, fără învelișul artistic, și conține un senzor de amprentă – odată identificată amprenta, ceva devine din mat transparent și o lucrare devine vizibilă, dar doar pentru cine a donat o amprentă.
Interacțiunea cu publicul are loc pentru ea în cel puțin două moduri: pe de o parte sunt cei care donează date, în urma unor apeluri. Sunt seturi de date fiziologice: pulsuri, unde cerebrale, conductivitatea pielii din acel moment. Sau modul în care reacționează cineva care e singur într-o încăpere cu o cameră video. Se simte în siguranță? Supravegheat? Toate aceste pachete de date sunt folosite pentru a crea, cu ajutorul inteligenței artificiale, obiecte artistice. Iar întâlnirea cu acest tip de public „donator” e un test și o etapă importantă, mai ales dacă folosește pentru prima dată o anumită tehnologie. Metodele sale sunt aceleași ca în cercetarea științifică: cu cât sunt mai multe seturi de date, cu atât se pot face reglaje mai fine. În cazul acvariului, de exemplu, primele teste au fost făcute cu pulsul ei, de 82 de bătăi pe minut. Dar când l-a testat cu pulsul unui coleg, de 70, a văzut că în partea stângă apa sărea afară din acvariu, așa că a trebuit să schimbe unghiul motorului astfel încât efectul să se păstreze și la un puls mai mic.
Pe de altă parte, e publicul care vine să vadă expozițiile și pe care nu prea-l poartă în minte când lucrează, iar acesta e unul dintre puținele elemente pe care le avem în comun în procesul nostru de lucru. De fiecare dată când expune are nesiguranțele ei legate de receptare, dar oricum nimeni nu spune nimic de rău, zice ea, e un schimb de nesiguranțe: ale ei de artistă și ale publicului care nu e din piața de artă.
Eu mormăi în barbă că numai pe scriitori îi spurcă publicul pe internet, dar nu am dreptate, cel puțin și în cazul filmului sunt păreri multe și viscerale. Mă întreb cum e mai bine, să fii expus părerilor (mai ales cu toate aceste scurtături pe care le oferă rețelele sociale) sau să fii deconectat, fiindcă ești într-o zonă mai puțin accesibilă publicului larg? Rumeg aceste gânduri când plec de la Malmaison și le mai rumeg și acum, scriind, dar n-am un răspuns.
Floriama îmi spune că cele mai fericite momente la o expoziție sunt cele în care vizitatorul e curios și te întreabă lucruri și nu trebuie să-l agasezi tu explicându-i. E sigură că și colegii artiști au o părere, dar foarte rar primești un feedback negativ de la ei. Ea numește această atitudine empatie, dar eu, fiind mai în vârstă (cu un an) și trecând printr-o perioadă mai acră a vieții, spun că e o lume mică și nu vrei relații proaste cu colegii și e singurul moment al întâlnirii în care vorbim una peste alta. Măcar ei să pot să-i spun ce simt! Cine știe mai târziu peste cine dai într-un moment de supraviețuire economică...
Plec din atelierul Floriamei un pic copleșită de bogăția lui, de coerența cu care vorbește ea, de perseverența care la unii se vede mai mult și la alții mai puțin, dar e acolo și e mereu necesară, de luciditatea cu care se observă ca artistă. „Mi-ar plăcea să fiu mai activistă decât sunt, dar n-aș vrea să mă iau prea în serios”, mi-a zis la un moment dat, printre altele. Merg către Eroilor pe Calea Plevnei și pe lângă ruina Casei Radio și-mi răsună în minte ecoul unei idei: că o inimă curată se obține după foarte, foarte multe încercări.
„𝐓𝐡𝐞 𝐒𝐨𝐦𝐚𝐭𝐢𝐬𝐭, 𝐓𝐡𝐞 𝐄𝐧𝐭𝐫𝐨𝐩𝐢𝐬𝐭 & 𝐓𝐡𝐞 𝐒𝐤𝐞𝐩𝐭𝐢𝐜”, un proiect de cercetare și producție artistică al Asociației Qolony, se va deschide sâmbată, 19 noiembrie de la ora 18, la Rezidența 9. Mai multe despre eveniment, aici.





